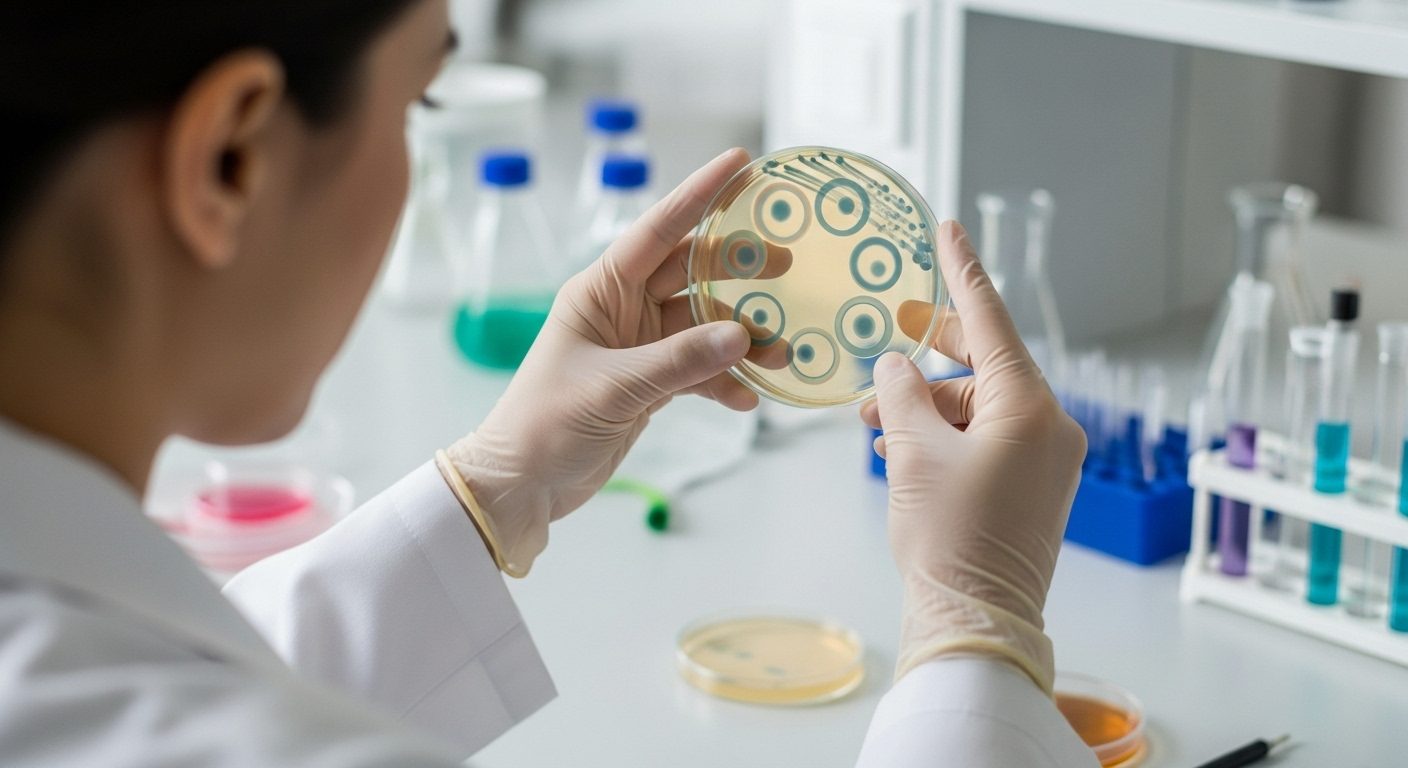
Un diagnostic précis pour une bataille ciblée

Son nom, aux consonances un peu barbares, ne dit sans doute rien à la plupart d’entre nous. Pourtant, Klebsiella pneumoniae est une bactérie bien plus commune qu’on ne le pense. Elle vit en nous, le plus souvent discrète et inoffensive, mais peut se transformer en un agent pathogène redoutable, surtout entre les murs des hôpitaux où elle est devenue un véritable casse-tête.
Une habitante naturelle de notre corps

À l’origine, Klebsiella pneumoniae est ce que les scientifiques appellent une bactérie commensale. En clair, elle fait partie du paysage de notre microbiote, colonisant les intestins ou les voies respiratoires de près d’un tiers de la population sans causer le moindre tort. On la retrouve aussi un peu partout dans l’environnement : sols, végétaux, et même dans l’eau. Une cohabitation généralement pacifique, jusqu’à ce qu’un déséquilibre se crée.
Quand l'alliée devient une menace

Le problème survient lorsque cette bactérie quitte son territoire habituel ou qu’elle rencontre un organisme affaibli. Elle peut alors provoquer une large gamme d’infections, parfois très sévères : pneumonies, infections urinaires, septicémies (infections du sang), ou encore des atteintes rénales. Les personnes les plus vulnérables, comme les personnes âgées, diabétiques, ou souffrant de maladies chroniques, sont ses cibles privilégiées en dehors du milieu hospitalier.
Le cauchemar des infections nosocomiales

C’est à l’hôpital que Klebsiella pneumoniae révèle son visage le plus sombre. Elle y est l’une des principales responsables des infections nosocomiales, celles que l’on contracte sur place. On estime qu’elle est en cause dans près de 8 % de ces infections en Europe et aux États-Unis. Les services de soins intensifs et de néonatalogie, où se trouvent les patients les plus fragiles, sont particulièrement touchés. La bactérie s’y propage, contaminant cathéters, sondes et sites opératoires.
Fièvre, frissons, brûlures : des symptômes multiples

Comment savoir si l’on est infecté ? Les signaux d’alerte dépendent bien sûr de la zone attaquée. Une forte fièvre, des frissons et une dégradation de l’état général sont des signes courants. S’il s’agit d’une pneumonie, une toux et des crachats s’y ajouteront. Dans le cas d’une infection urinaire, ce sont plutôt des brûlures en urinant et une envie pressante et fréquente qui doivent alerter. Dans les cas les plus rares et graves, elle peut même causer une méningite, avec maux de tête violents et troubles de la conscience.
Un diagnostic précis pour une bataille ciblée
Pour confirmer l’infection, il n’y a pas de secret : il faut passer par le laboratoire. Des prélèvements de sang, d’urine ou de sécrétions permettent d’isoler la bactérie et de l’identifier formellement. Mais cette étape n’est que la moitié du chemin. L’essentiel est de réaliser un antibiogramme. Cette analyse cruciale permet de tester la sensibilité de la souche bactérienne aux différents antibiotiques. Une information vitale, car comme nous allons le voir, toutes les souches de Klebsiella pneumoniae ne se valent pas.
La transmission : une affaire de mains

Comment cet ennemi se propage-t-il, notamment à l’hôpital ? La réponse est aussi simple que glaçante : par les mains. Klebsiella pneumoniae est une bactérie dite « manuportée ». Elle voyage d’un patient à l’autre, d’une surface contaminée à un malade, le plus souvent via les mains du personnel soignant. Cela souligne, si besoin était, l’importance capitale et non négociable de l’hygiène des mains en milieu de soins.
le défi de la résistance aux antibiotiques

Le véritable défi que pose Klebsiella pneumoniae aujourd’hui est sa redoutable capacité à résister aux antibiotiques. L’OMS l’a d’ailleurs classée parmi les agents pathogènes prioritaires face auxquels il est urgent de trouver de nouvelles armes. Certaines souches produisent des enzymes, comme les carbapénémases, capables de neutraliser nos antibiotiques les plus puissants. Dans certains pays, les traitements échouent déjà pour la moitié des patients infectés. Une course contre la montre est bel et bien engagée.
Selon la source : passeportsante.net










